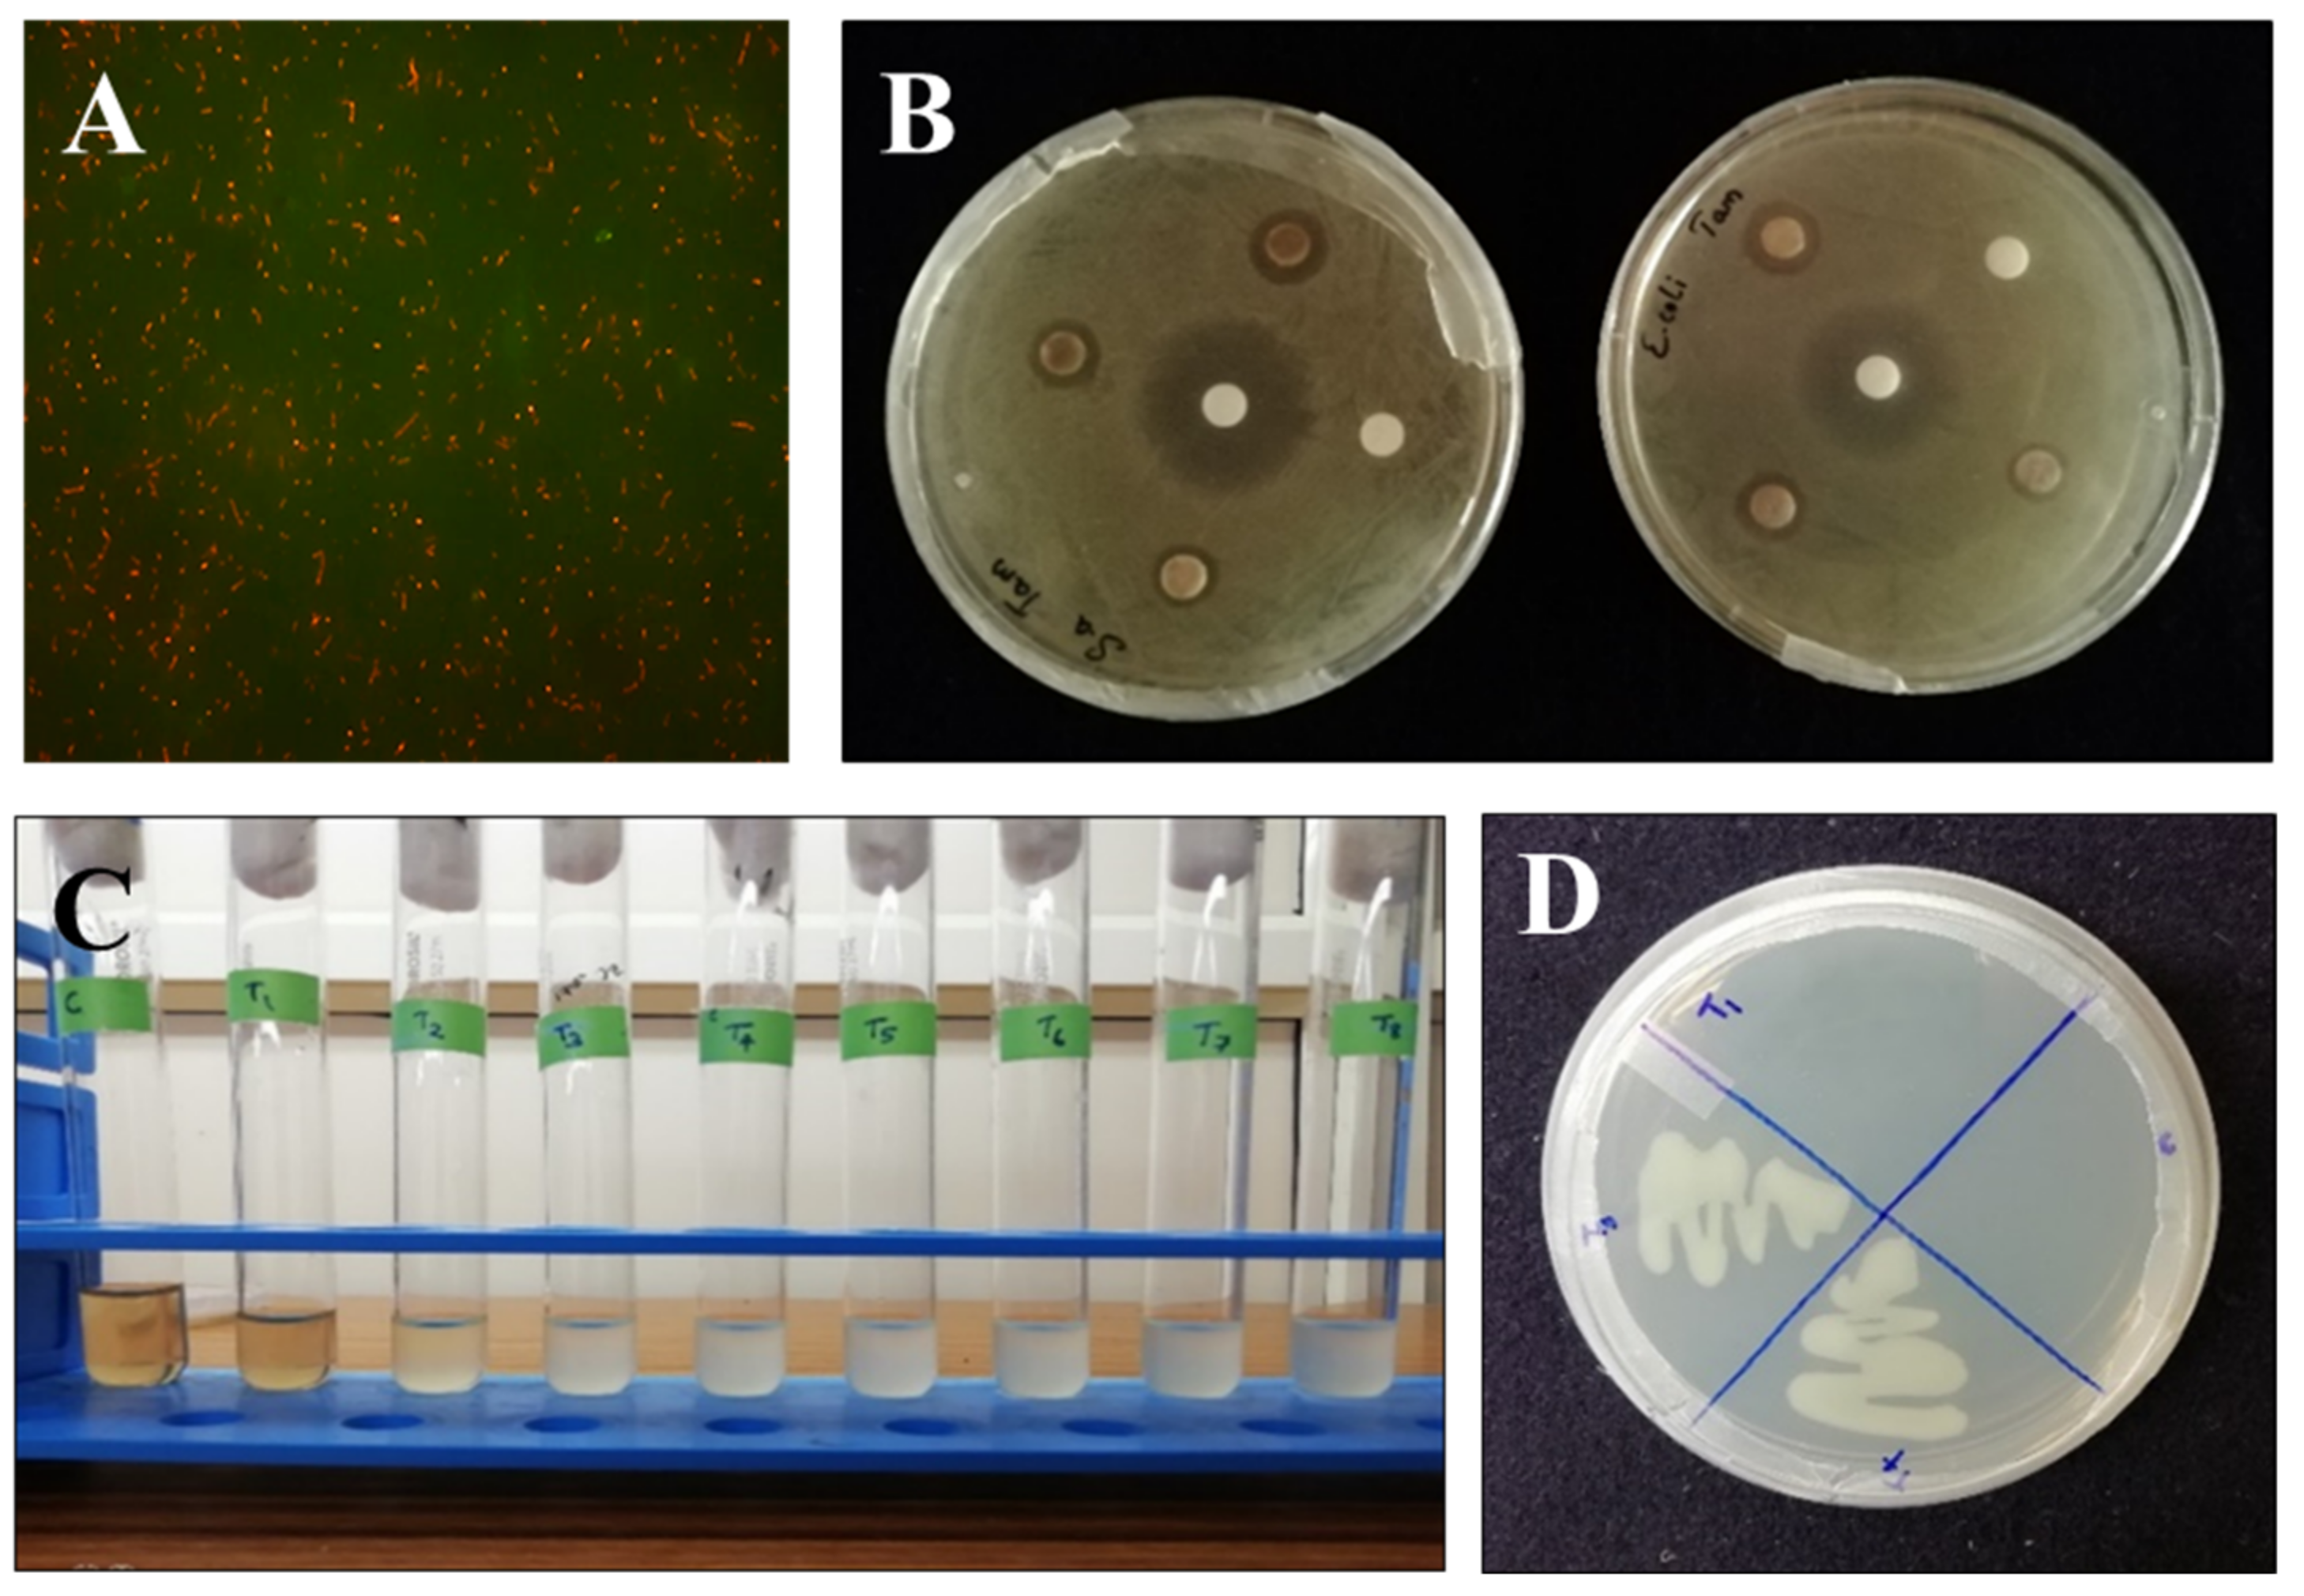
Biomolecules 11 00259 g005
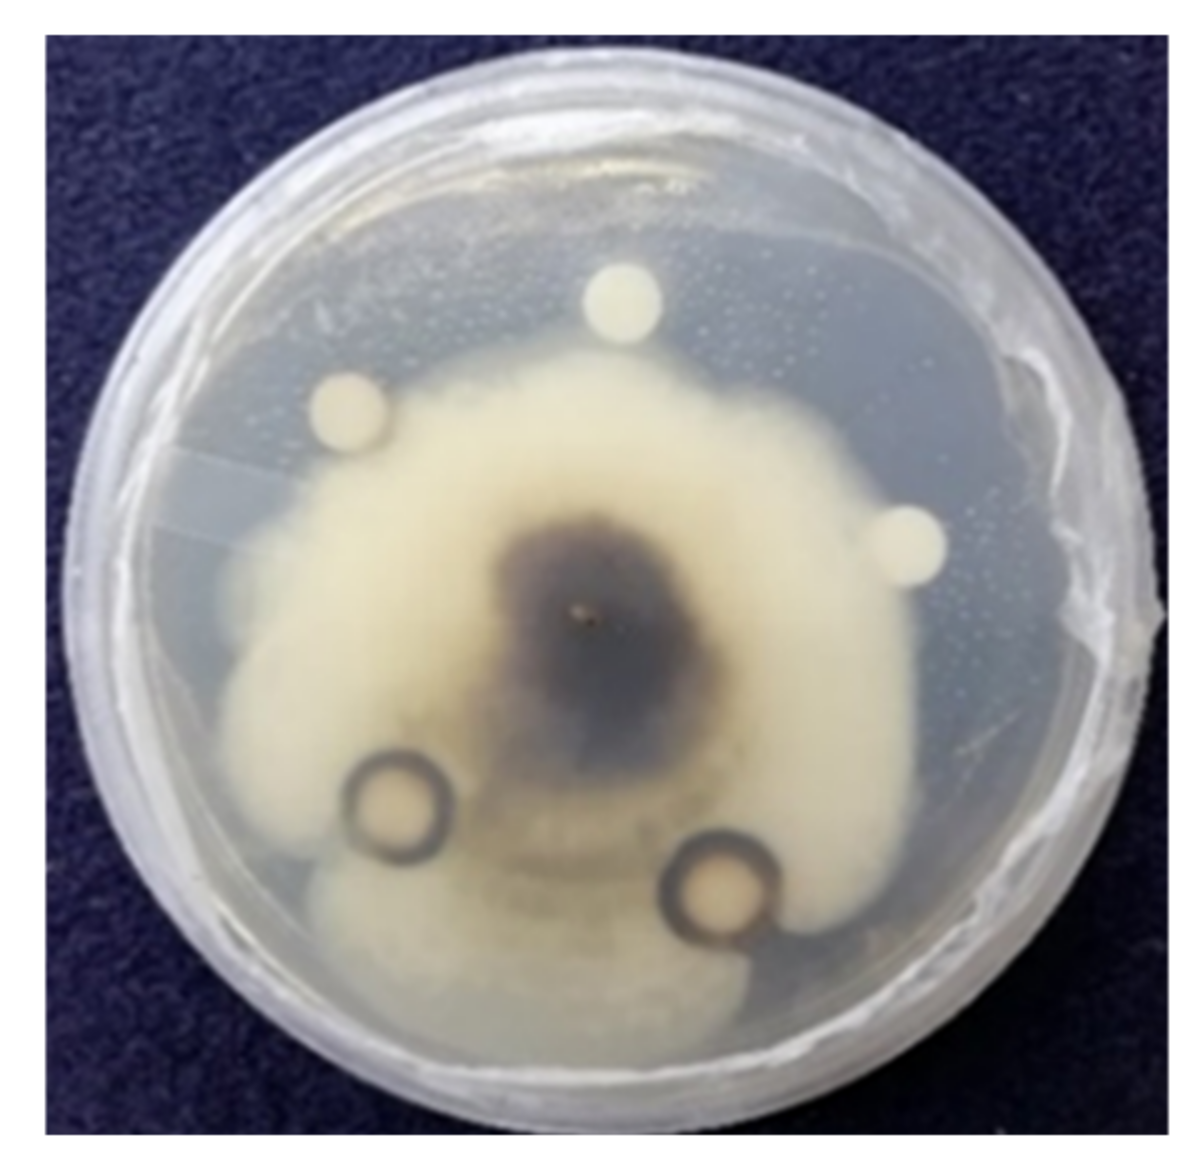
Biomolecules 11 00259 g007

Green Synthesis of Silver Nanoparticles by Cytobacillus firmus Isolated from the Stem Bark of Terminalia arjuna and Their Antimicrobial Activity
Abstract
1. Introduction
2. Materials and Methods
2.1. Collection of the Bark Sample of Terminalia arjuna
2.2. Isolation and Identification of Endophytic Bacteria
2.3. Molecular Identification of Endophytic Bacteria
2.4. Screening of Endophytic Bacteria for the Synthesis of Silver Nanoparticles
2.5. Physical Characterization
2.5.1. UV–Visible Spectroscopy
2.5.2. FTIR Spectroscopy
2.5.3. Fluorescent Microscopy
2.5.4. Scanning Electron Microscope (SEM)
2.5.5. Dynamic Light Scattering (DLS)
2.5.6. XRD Analysis
2.6. Biological Activity of Silver Nanoparticles
2.6.1. Antibacterial Assay
2.6.2. Antifungal Assay by Disc Diffusion Method
2.6.3. Preparation of Platelets
2.6.4. Evaluation of Platelet Viability by MTT Assay
2.6.5. Isolation of Human Erythrocytes/RBCs
2.6.6. Hemolysis Assay
3. Results and Discussion
3.1. Isolation and Identification of Endophytic Bacteria from Terminalia arjuna
3.2. Molecular Identification of Endophytic Bacteria
3.3. Screening of Cytobacillus firmus for the Synthesis of Silver Nanoparticles
3.4. Physical Characterization
3.4.1. UV–Visible Spectroscopy
3.4.2. Fourier Transform Infrared Spectroscopy (FTIR)
3.4.3. Dynamic Light Scattering (DLS)
3.4.4. XRD Analysis
3.4.5. Scanning Electron Microscopy (SEM)
3.5. Biological Studies
3.5.1. Fluorescent Microscopy
3.5.2. Antibacterial Test Using Disc Diffusion Method
3.5.3. Antifungal Activity of AgNPs against Magnaporthe grisea
3.5.4. Evaluation of Platelet Viability by MTT Assay
3.5.5. Hemolysis Assay on Human Erythrocytes
4. Conclusions
Author Contributions
Funding
Institutional Review Board Statement
Informed Consent Statement
Data Availability Statement
Acknowledgments
Conflicts of Interest
References
- Sharma, D.; Kanchi, S.; Bisetty, K. Biogenic synthesis of nanoparticles: A review. Arab. J. Chem. 2019, 12, 3576–3600. [Google Scholar] [CrossRef]
- Barrow, J.R.; Lucero, M.E.; Reyes-Vera, I.; Havstad, K.M. Do symbiotic microbes have a role in regulating plant performance and response to stress? Commun. Integr. Biol. 2008, 1, 69–73. [Google Scholar] [CrossRef] [PubMed]
- Uzma, F.; Mohan, C.D.; Hashem, A.; Konappa, N.M.; Rangappa, S.; Kamath, P.V.; Singh, B.P.; Mudili, V.; Gupta, V.K.; Siddaiah, C.N.; et al. Endophytic Fungi—Alternative Sources of Cytotoxic Compounds: A Review. Front. Pharmacol. 2018, 9. [Google Scholar] [CrossRef]
- Uzma, F.; Mohan, C.D.; Siddaiah, C.N.; Chowdappa, S. Endophytic Fungi: Promising Source of Novel Bioactive Compounds. In Advances in Endophytic Fungal Research: Present Status and Future Challenges; Singh, B.P., Ed.; Springer International Publishing: Cham, Switzerland, 2019; pp. 243–265. [Google Scholar] [CrossRef]
- Rani, R.; Sharma, D.; Chaturvedi, M.; Yadav, J. Green synthesis, characterization and antibacterial activity of silver nanoparticles of endophytic fungi Aspergillus terreus. J. Nanomed. Nanotechnol. 2017, 8. [Google Scholar] [CrossRef]
- Anusha, S.; Cp, B.; Mohan, C.D.; Mathai, J.; Rangappa, S.; Mohan, S.; Chandra; Paricharak, S.; Mervin, L.; Fuchs, J.E.; et al. A Nano-MgO and Ionic Liquid-Catalyzed ‘Green’ Synthesis Protocol for the Development of Adamantyl-Imidazolo-Thiadiazoles as Anti-Tuberculosis Agents Targeting Sterol 14α-Demethylase (CYP51). PLoS ONE 2015, 10, e0139798. [Google Scholar] [CrossRef]
- Baburajeev, C.P.; Mohan, C.D.; Patil, G.S.; Rangappa, S.; Pandey, V.; Sebastian, A.; Fuchs, J.E.; Bender, A.; Lobie, P.E.; Basappa; et al. Nano-cuprous oxide catalyzed one-pot synthesis of a carbazole-based STAT3 inhibitor: A facile approach via intramolecular C–N bond formation reactions. RSC Adv. 2016, 6, 36775–36785. [Google Scholar] [CrossRef]
- Shah, M.; Fawcett, D.; Sharma, S.; Tripathy, S.K.; Poinern, G.E.J. Green Synthesis of Metallic Nanoparticles via Biological Entities. Materials 2015, 8, 7278–7308. [Google Scholar] [CrossRef] [PubMed]
- Singh, J.; Dutta, T.; Kim, K.-H.; Rawat, M.; Samddar, P.; Kumar, P. ‘Green’ synthesis of metals and their oxide nanoparticles: Applications for environmental remediation. J. Nanobiotechnol. 2018, 16, 84. [Google Scholar] [CrossRef]
- Siddaiah, C.N.; Prasanth, K.V.H.; Satyanarayana, N.R.; Mudili, V.; Gupta, V.K.; Kalagatur, N.K.; Satyavati, T.; Dai, X.-F.; Chen, J.-Y.; Mocan, A.; et al. Chitosan nanoparticles having higher degree of acetylation induce resistance against pearl millet downy mildew through nitric oxide generation. Sci. Rep. 2018, 8, 2485. [Google Scholar] [CrossRef] [PubMed]
- Popli, D.; Anil, V.; Subramanyam, A.B.; Namratha, M.N.; Ranjitha, V.R.; Rao, S.N.; Rai, R.V.; Govindappa, M. Endophyte fungi, Cladosporium species-mediated synthesis of silver nanoparticles possessing in vitro antioxidant, anti-diabetic and anti-Alzheimer activity. Artif. Cells Nanomed. Biotechnol. 2018, 46, 676–683. [Google Scholar] [CrossRef]
- Elbeshehy, E.K.F.; Elazzazy, A.M.; Aggelis, G. Silver nanoparticles synthesis mediated by new isolates of Bacillus spp., nanoparticle characterization and their activity against Bean Yellow Mosaic Virus and human pathogens. Front. Microbiol. 2015, 6, 453. [Google Scholar] [CrossRef] [PubMed]
- Sunkar, S.; Nachiyar, C.V. Biogenesis of antibacterial silver nanoparticles using the endophytic bacterium Bacillus cereus isolated from Garcinia xanthochymus. Asian Pac. J. Trop. Biomed. 2012, 2, 953–959. [Google Scholar] [CrossRef]
- Li, G.; He, D.; Qian, Y.; Guan, B.; Gao, S.; Cui, Y.; Yokoyama, K.; Wang, L. Fungus-mediated green synthesis of silver nanoparticles using Aspergillus terreus. Int. J. Mol. Sci. 2012, 13, 466–476. [Google Scholar] [CrossRef] [PubMed]
- Kowshik, M.; Ashtaputre, S.; Kharrazi, S.; Vogel, W.; Urban, J.; Kulkarni, S.K.; Paknikar, K.M. Extracellular synthesis of silver nanoparticles by a silver-tolerant yeast strain MKY3. Nanotechnology 2002, 14, 95–100. [Google Scholar] [CrossRef]
- Ahmed, S.; Ahmad, M.; Swami, B.L.; Ikram, S. A review on plants extract mediated synthesis of silver nanoparticles for antimicrobial applications: A green expertise. J. Adv. Res. 2016, 7, 17–28. [Google Scholar] [CrossRef] [PubMed]
- Iravani, S.; Korbekandi, H.; Mirmohammadi, S.V.; Zolfaghari, B. Synthesis of silver nanoparticles: Chemical, physical and biological methods. Res. Pharm. Sci. 2014, 9, 385. [Google Scholar] [PubMed]
- Patra, J.K.; Baek, K.-H. Green nanobiotechnology: Factors affecting synthesis and characterization techniques. J. Nanomater. 2014, 2014, 417305. [Google Scholar] [CrossRef]
- Idris, A.B.; Hassan, H.G.; Ali, M.A.S.; Eltaher, S.M.; Idris, L.B.; Altayb, H.N.; Abass, A.M.; Ibrahim, M.M.A.; Ibrahim, E.M.; Hassan, M.A. Molecular Phylogenetic Analysis of 16S rRNA Sequences Identified Two Lineages of Helicobacter pylori Strains Detected from Different Regions in Sudan Suggestive of Differential Evolution. Int. J. Microbiol. 2020, 2020, 8825718. [Google Scholar] [CrossRef]
- Rakesh, K.S.; Jagadish, S.; Vinayaka, A.C.; Hemshekhar, M.; Paul, M.; Thushara, R.M.; Sundaram, M.S.; Swaroop, T.R.; Mohan, C.D.; Basappa; et al. A New Ibuprofen Derivative Inhibits Platelet Aggregation and ROS Mediated Platelet Apoptosis. PLoS ONE 2014, 9, e107182. [Google Scholar] [CrossRef]
- Shrivastava, S.; Bera, T.; Singh, S.K.; Singh, G.; Ramachandrarao, P.; Dash, D. Characterization of antiplatelet properties of silver nanoparticles. Acs Nano 2009, 3, 1357–1364. [Google Scholar] [CrossRef]
- Do, V.Q.; Park, K.H.; Park, J.M.; Lee, M.Y. Comparative In Vitro Toxicity Study of Docetaxel and Nanoxel, a Docetaxel-Loaded Micellar Formulation Using Cultured and Blood Cells. Toxicol. Res. 2019, 35, 201–207. [Google Scholar] [CrossRef] [PubMed]
- Kumar, K.H.; Paricharak, S.; Mohan, C.D.; Bharathkumar, H.; Nagabhushana, G.P.; Rajashekar, D.K.; Chandrappa, G.T.; Bender, A.; Basappa; Rangappa, K.S. Nano-MoO3-mediated synthesis of bioactive thiazolidin-4-ones acting as anti-bacterial agents and their mode-of-action analysis using in silico target prediction, docking and similarity searching. New J. Chem. 2016, 40, 2189–2199. [Google Scholar] [CrossRef]

| Concentrations of AgNPs (µg/µL) | Zone of Inhibition (mm) | |
|---|---|---|
| Escherichia coli | Staphylococcus aureus | |
| 5 | 12 | 11 |
| 10 | 15 | 15 |
| 20 | 18 | 20 |
| Streptomycin | 24 | 23 |
| Test Samples | Concentration of AgNPs (µg/mL) | OD Values (600 nm) | Mean | Standard Deviation | Mean + SD | ||
|---|---|---|---|---|---|---|---|
| T1 | 150 | 0.099 | 0.097 | 0.099 | 0.098 | 0.1918 | 0.289 |
| T2 | 50 | 0.150 | 0.153 | 0.152 | 0.151 | 0.1717 | 0.322 |
| T3 | 16.6 | 0.573 | 0.575 | 0.575 | 0.574 | 0.0118 | 0.585 |
| T4 | 5.53 | 0.855 | 0.855 | 0.857 | 0.855 | 0.0938 | 0.948 |
| T5 | 1.84 | 0.810 | 0.790 | 0.800 | 0.8 | 0.0728 | 0.872 |
| T6 | 0.61 | 0.851 | 0.853 | 0.852 | 0.852 | 0.0927 | 0.944 |
| T7 | 0.202 | 0.690 | 0.720 | 0.700 | 0.703 | 0.0360 | 0.739 |
| T8 | 0.06 | 0.818 | 0.820 | 0.818 | 0.818 | 0.08 | 0.898 |
Publisher’s Note: MDPI stays neutral with regard to jurisdictional claims in published maps and institutional affiliations. |
© 2021 by the authors. Licensee MDPI, Basel, Switzerland. This article is an open access article distributed under the terms and conditions of the Creative Commons Attribution (CC BY) license (http://creativecommons.org/licenses/by/4.0/).
Share and Cite
Sudarsan, S.; Kumar Shankar, M.; Kumar Belagal Motatis, A.; Shankar, S.; Krishnappa, D.; Mohan, C.D.; Rangappa, K.S.; Gupta, V.K.; Siddaiah, C.N. Green Synthesis of Silver Nanoparticles by Cytobacillus firmus Isolated from the Stem Bark of Terminalia arjuna and Their Antimicrobial Activity. Biomolecules 2021, 11, 259. https://doi.org/10.3390/biom11020259
Sudarsan S, Kumar Shankar M, Kumar Belagal Motatis A, Shankar S, Krishnappa D, Mohan CD, Rangappa KS, Gupta VK, Siddaiah CN. Green Synthesis of Silver Nanoparticles by Cytobacillus firmus Isolated from the Stem Bark of Terminalia arjuna and Their Antimicrobial Activity. Biomolecules. 2021; 11(2):259. https://doi.org/10.3390/biom11020259
Chicago/Turabian StyleSudarsan, Sujesh, Madan Kumar Shankar, Anil Kumar Belagal Motatis, Sushmitha Shankar, Darshan Krishnappa, Chakrabhavi Dhananjaya Mohan, Kanchugarakoppal S. Rangappa, Vijai Kumar Gupta, and Chandra Nayaka Siddaiah. 2021. "Green Synthesis of Silver Nanoparticles by Cytobacillus firmus Isolated from the Stem Bark of Terminalia arjuna and Their Antimicrobial Activity" Biomolecules 11, no. 2: 259. https://doi.org/10.3390/biom11020259
APA StyleSudarsan, S., Kumar Shankar, M., Kumar Belagal Motatis, A., Shankar, S., Krishnappa, D., Mohan, C. D., Rangappa, K. S., Gupta, V. K., & Siddaiah, C. N. (2021). Green Synthesis of Silver Nanoparticles by Cytobacillus firmus Isolated from the Stem Bark of Terminalia arjuna and Their Antimicrobial Activity. Biomolecules, 11(2), 259. https://doi.org/10.3390/biom11020259

